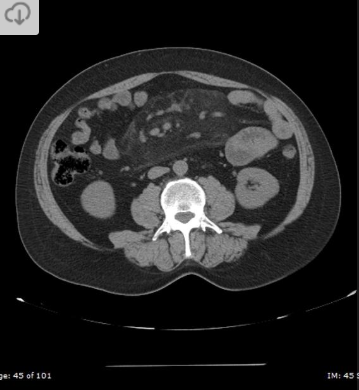

Homem, 45 anos, Dor abdominal, distensão e parada da eliminação de fezes e flatos.

Hérnia interna - pericecal.
Causa de obstrução intestinal de delgado.
Segundo tipo mais comum de hérnia interna, perdendo para a paraduodenal.
A alça herniada geralmente consiste em um segmento ileal que se projeta através de um defeito no mesentério cecal (que pode ser congênito ou adquirido)
Masculino, 62 anos, 2 dias após colecistectomia.

Material hemostático na fossa da vesícula biliar pós colecistectomia.
Aspecto de bolhas de gás distribuidas de forma linear, uniformemente compactadas.
Sem realce da parede e sem nível liquido (diferente do abscesso)
Pode mascarar complicações da cirurgia (ex perfuração duodenal). Neste caso havia perfuração duodenal mascarada pelo material, que ao ser reabsorvido (5 dias após), deixou evidente o pneumoperitôneo e o extravasamento de contraste oral para a fossa da vesícula biliar.

64 anos, mulher com Dor abdominal intensa

Hérnia de spiegel com sinais de estrangulamento
Colo herniário na linha semilunar, separando os músculos reto abdominal e transverso
Hérnias de spiegel tem alto risco de encarceramento (margens afiadas).
Neste caso a hérnia continha gordura omental e mostrava sinais de estrangulamento: densificação da gordura e liquido no interior do saco herniário.
Homem, 74 anos, fibrilação atrial.
Dor abdominal aguda.

Infarto tromboembólico da artéria renal direita.
Região hipodensa com defeito de realce em forma de cunha.
Sinal do realce cortical ocorre geralmente após 24 horas do infarto e consiste no realce da margem periférica do rim na fase nefrográfica, no contexto isquemico. Ocorre em cerca de 50% dos casos.
Homem, 57 anos, história de pancreatite crônica

Pseudoaneurisma da artéria mesentérica superior
Separação da camada média e da adventícia na parede da artéria (diferente do aneurisma, que seria a dilatação das três paredes do vaso). Pode ocorrer por aterosclerose, trauma, inflamação (como neste caso).
Pode estar associado à ruptura (pseudoaneurisma tem risco muito maior que de um aneurisma).
Mulher, 28 anos; dor abdominal.

Mesenterite esclerosante (paniculte, mesenterite retrátil)
Doença crônica idiopática inflamatória da gordura mesentérica. Predomínio em idosos;
Sinal do mesentério enevoado: densificação da gordura com formação de uma pseudocápsula; poupa a gordura ao redor dos vasos do mesentério; pode ter linfonodos mesentéricos aumentados;
Pode estar associado à malignidade como câncer de mama, pulmão, linfoma;
Tratamento inicial envolve corticoterapia; Seguimento envolve queda dos marcadores inflamatórios: PCR, VHS.
60 anos, Dor abdominal;
Mesenterite esclerosante (paniculte, mesenterite retrátil)
Doença crônica idiopática inflamatória da gordura mesentérica. Predomínio em idosos;
Sinal do mesentério enevoado: densificação da gordura com formação de uma pseudocápsula; poupa a gordura ao redor dos vasos do mesentério; pode ter linfonodos mesentéricos aumentados;
Pode estar associado à malignidade como câncer de mama, pulmão, linfoma;
Tratamento inicial envolve corticoterapia; Seguimento envolve queda dos marcadores inflamatórios: PCR, VHS.
65 anos, Dor abdominal.
Aumento de PCR e VHS.

Mesenterite esclerosante (paniculte, mesenterite retrátil)
Doença crônica idiopática inflamatória da gordura mesentérica. Predomínio em idosos;
Sinal do mesentério enevoado: densificação da gordura com formação de uma pseudocápsula; poupa a gordura ao redor dos vasos do mesentério; pode ter linfonodos mesentéricos aumentados;
Pode estar associado à malignidade como câncer de mama, pulmão, linfoma;
Tratamento inicial envolve corticoterapia; Seguimento envolve queda dos marcadores inflamatórios: PCR, VHS.
64 anos, Maculino
Dor abdominal

Diverticulite do sigmóide complicada com abscesso.
Massa inflamatória sugestiva de abscesso contendo nível liquido e densificação da gordura do mesentério adjacente.
Divertículos no sigmóide podem ser observados.
2 anos; masculino; respiração ruidosa desde o nascimento.

Cisto de duplicação esofágico
Predleção por meninos; diagnosticados na infância
Em geral assintomáticos; podem provocar estridor
Mais comuns no esôfago distal; geralmente não comunicam com a luz do esôfago;
TC: Cisto com densidade de líquido, margens bem definidas que podem realçar com contraste; podem complicar com hemorragia, infecção: nível liquido, espessamento parietal.

Sangramento gastrointestinal por angiodisplasia
É notado um extravasamento de contraste para o interior do lúmen do colon durante a fase arterial.
Não se observam sinais inflamatórios ou neoplásicos.
6 anos; vomitos

Má-rotação intestinal
Duodeno não cruza para a esquerda;
Intestino delgado fica enrolado no lado direito do abdome e o colon à esquerda.
Mulher, 55 anos;
Após comer peixe

Perfuração esofágica;
Extensa quantidade de ar no mediastino e no interior da parede do esôfago (em topografia da submucosa, entre a mucosa e a muscular);
O ar extende para o retroperitôneo inferiormente.

Varizes esofágicas
Multiplas imagens tubulares contrastantes, de densidade semelhante à aorta adjacente, ao lado do esôfago.

Divertículo de fundo gástrico
Divertículo congênito que se forma no fundo gástrico e se projeta para posterior, em topografia de adrenal esquerda, simulando massa adrenal.
A presença de gás ou contraste oral no interior do divertículo confirma a etiologia
A identificação do colo comunicando com o fundo gástrico também ajuda.

Cisto de duplicação gástrico
Massa de limites bem definidos, de conteúdo homogêneo com densidade de líquido (20 - 30 UH), sem comunicação com a luz do estômago, porém em íntimo contato com sua parede.
Pode se projetar para posterior, na topografia da adrenal esquerda.

GIST gástrico
Tumor do estroma gastointestinal; maioria benignos; local mais comum: estôamgo; Predleção por pacientes > 50 anos;
TC: Massa grande, na parede, podendo ser endoluminal ou exofítica, com densidade de partes moles, homogênea (< 3 cm) ou com centro necrosado (quando grandes), com realce periférico; podem apresentar uma cratera ulcerosa, que é preenchida por contraste oral e pode formar nível dentro dela.

Lipoma gástrico causando intussuscepção.
Dispepsia

LINFOMA MALT GÁSTRICO
Dor abdominal, distensão;

Hérnia do obturador;
Alça de delgado presa entre o músculo pectíneo e o obturador externo;
Febre, Dor lombar

Nefrograma estriado - fase excretora
Pielonefrite aguda.
Fibrilação atrial; Dor lombar

Infarto renal.
Opacidade triangular em cunha; realce cortical periférico.

Hemossiderose hepática secundária à hemotransfusões
Fígado hiperatenuante
Linfonodos hiperdensos no hilo hepático
Esplenomegalia.


